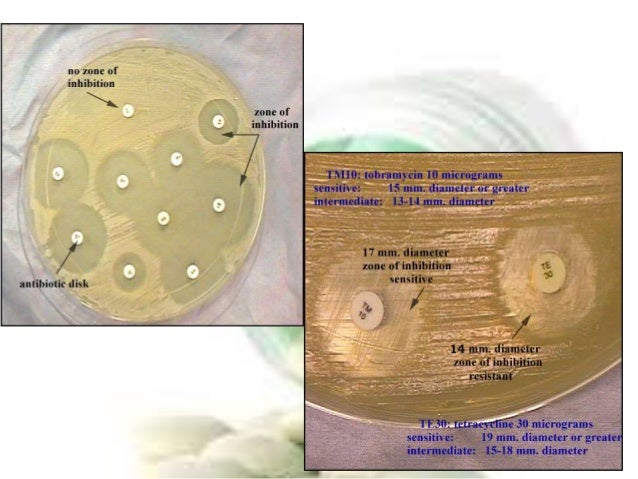

Sensitivity to antibiotics was tested by the disk diffusion method and performed in Mueller–Hinton agar. Arc. pyogenes strains were the most sensitive to amoxicillin/clavulanic acid (Amc) (97.3%), bacitracin (96.7%), ceftiofur (95.8%) and cephapirin (77.5%).
Is arc pyogenes sensitive to antibiotics?
Sensitivity to antibiotics was tested by the disk diffusion method and performed in Mueller-Hinton agar. Arc. pyogenes strains were the most sensitive to amoxicillin/clavulanic acid (Amc) (97.3%), bacitracin (96.7%), ceftiofur (95.8%) and cephapirin (77.5%).
Which antimicrobials are most effective against T pyogenes?
Benzylpenicillin and ampicillin were the most active antibiotics, with MIC ranges of < or = 0.0125-0.05 microgram/ml for bo … Antimicrobial susceptibility of Arcanobacterium pyogenes isolated from cattle and pigs
What antibiotics are used to treat Arcanobacterium haemolyticum?
Sep 09, 2011 · All 29 A. pyogenes strains included in the current study were sensitive to ceftiofur, spectinomycin, tiamulin, and trimethoprim–sulfamethoxazole with MIC values of ≤0.25 mg/l, ≤1 mg/l, ≤16 mg/l, and ≤2 mg/l, respectively. Also, all the isolates were either fully or intermediately susceptible to gentamycin and tulathromycin.
Which physical findings are characteristic of Arcanobacterium haemolyticum pharyngitis?
Abstract The susceptibilities of 138 clinical isolates of Arcanobacterium haemolyticum to 11 antimicrobial agents were tested. All strains were susceptible to phenoxymethylpenicillin, cephalosporins, erythromycin, azithromycin, clindamycin, vancomycin, doxycycline, and ciprofloxacin but were resistant to trimethoprim-sulfamethoxazole. Full text
What is Trueperella pyogenes?
Trueperella (T.) pyogenes is an opportunistic pathogen that causes suppurative diseases in domestic animals. In this work, the properties, pathogenesis and phenotypic diversity of T. pyogenes isolates from bovine mastitis were studied. Both pyolysin (plo) and collagen-binding protein (cbp) virulence factor genes were detected by PCR in all T. pyogenes isolates (n = 50). Using the tissue culture plate method, 90% of T. pyogenes isolates were able to form biofilms. The minimum inhibitory concentrations (MICs) of 13 antimicrobials against T. pyogenes isolates were determined. High susceptibility was observed to rifampin (96%), ampicillin (94%), ciprofloxacin (94%), and penicillin (92%), while low susceptibility was found to trimethoprim-sulphamethoxazole (10%) and bacitracin (2%). The intracellular assay revealed that T. pyogenes isolates had different cytopathogenic effects on cells. The high percentage (28.6%) of T. pyogenes isolates suggests that this bacterium is an important contributor to mastitis. Moreover, the high occurrence of multidrug resistance, biofilm production, intracellular survival, and the temporal dynamics of T. pyogenes interactions are key factors for a better understanding of how immunity acts on infections with these bacteria and how they evade immune surveillance, thus highlighting the need for the prudent use of antimicrobial agents in veterinary medicine.
What is the role of Trueperella pyogenes in mastitis?
Background: Trueperella pyogenes is one of the most clinically imperative bacteria responsible for severe cases of mastitis and metritis, particularly in postpartum dairy cows. The bacterium has emergence of antibiotic resistance and virulence characters. The existing research was done to apprise the phenotypic and genotypic evaluation of antibiotic resistance and characterization of virulence factors in the T. pyogenes bacteria of bovine mastitis and metritis in postpartum cows. Methods: Two-hundred and twenty-six bovine mastitic milk and 172 uterine swabs were collected and transferred to laboratory. Samples were cultured and T. pyogenes isolates were subjected to disk diffusion and DNA extraction. Distribution of virulence and antibiotic resistance genes was studied by PCR. Results: Thirty-two out of 226 (14.15%) mastitic milk and forty-one out of 172 (23.83%) uterine swab samples were positive for T. pyogenes. Isolates of mastitic milk harbored the highest prevalence of resistance toward gentamicin (100%), penicillin (100%), ampicillin (90.62%), amoxicillin (87.50%) and trimethoprim-sulfamethoxazole (87.50%), while those of metritis harbored the highest prevalence of resistance toward ampicillin (100%), amoxicillin (100%), gentamicin (97.56%), penicillin (97.56%) and cefalexin (97.56%). AacC, aadA1, aadA2 and tetW were the most generally perceived antibiotic resistance genes. All bacteria harbored plo (100%) and fimA (100%) virulence factors. NanP, nanH, fimC and fimE were also the most generally perceived virulence factors. Conclusions: All bacteria harbored plo and fimA virulence factors which showed that they can use as specific genetic markers with their important roles in pathogenicity of T. pyogenes bacteria. Phenotypic pattern of antibiotic resistance was confirmed by genotypic characterization of antibiotic resistance genes.
What are the Actinomycetaceae?
Actinomycetaceae, the only family classified in the order Actinomycetales of the phylum Actinobacteria, embraces the genera Actinomyces, Actinobaculum, Arcanobacterium, Mobiluncus, Trueperella, and Varibaculum. Of these genera, the genus Actinomyces has been indicated to be quite diverse, and in a phylogenetic tree based upon 16S rRNA, it showed polyphyletic branching into a number of different clusters and individual lineges. Therefore, it is evident that the generic limits within the family are still uncertain, and although the genera Actinobaculum, Arcanobacterium, Mobiluncus, Trueperella, and Varibaculum have been studied in considerable detail, their relationship to the lesser known hypothetical genera is still unresolved. Members of the family are defined by a wide range of morphological and chemotaxonomic properties, such as polar lipids, fatty acids, amino acids of peptidoglycan, and whole-cell sugars which are used for the delineation of genera and species. Although many of the species of Actinomycetaceae have been extensively studied, using standard biochemical tests, the applicability of such tests have remained limited because the results are often irreproducible. The family harbors many important species which can be found in a wide range of habitats including human, animal, and environmental. Many of these species have been proven to be the casual agents of many human and animal infections. © 2014 Springer-Verlag Berlin Heidelberg. All rights are reserved.
What antibiotics are used for uterine microbiota?
Broad-spectrum antibiotics such as ceftiofur and ampicillin are recommended for the treatment of metritis in dairy cows. Nonetheless, little is known about the impacts of antibiotics on the uterine microbiota. Here, we evaluated the shift in uterine microbiota after treating metritic cows with ceftiofur or ampicillin, and also gained insight into the uterine microbiota associated with cure of metritis. Uterine swabs from ceftiofur-treated, ampicillin-treated, and untreated metritic Holstein cows were collected on the day of metritis diagnosis (D1) and on D6 and then used for genomic DNA extraction and sequencing of the V4 hypervariable region of the 16S rRNA gene on the Illumina MiSeq platform. The uterine microbiota consolidated over time by decreasing species richness and increasing evenness; therefore, becoming more homogeneous. The uterine microbial community showed distinct clustering patterns on D6 according to antibiotic treatment, which could be attributed to more dynamic changes in the microbial structure from D1 to D6 in ceftiofur-treated cows. Ceftiofur led to significant changes at the community level, phylum level, and genus level, whereas the changes in ampicillin and untreated cows, although following the same pattern, were mostly non-significant. Bacteroidetes was significantly increased in ceftiofur-treated cows but was not changed after ampicillin and no treatment. Different responses to antibiotics were observed in Porphyromonas, which increased in relative abundance with ceftiofur and decreased with ampicillin. Regardless of treatment group, failure to cure metritis was associated with a decrease in diversity of uterine microbiota and an increase in the relative abundance of Bacteroides, Porphyromonas, and Fusobacterium.
What is the epidemiology of pyelonephritis in dairy cows?
The primary objective of this study is to assess the risk of catheterization for urine sampling in dairy cattle . The secondary objectives are to describe the epidemiology and risk factors of pyelonephritis in Israeli dairy cattle. The research is a retrospective case control study conducted on Israeli dairy cows that calved during a seven years period in three commercial dairy herds treated by the ambulatory clinic of the Koret school of Veterinary Medicine. Seven-four cases of pyelonephritis (incidence=1.05%) were diagnosed during the study period. Forty percent of the cases were diagnosed during the first month of lactation; parity (Odds Ratio (OR) for 2 nd and 3 rd lactation or more cow = 2.381 and 2.891, respectively), twin calving, endometritis and ketosis (OR=2.927, 1.693 and 2.206, respectively) were associated with pyelonephritis in the study population. Urethral catheterization was not significantly associated with pyelonephritis. Forty-four urine samples were cultured. Escherichia coli was the most prevalent bacteria isolated from urine (30 cases; 65.9%). The second most prevalent bacteria were Proteus Mirabilis (6 cases; 13.6%). It was concluded that pyelonephritis of dairy cows is associated with calving diseases. The risk of contracting pyelonephritis increases with age. Urethral catheterization was not associated with increased pyelonephritis risk. The initial treatment of pyelonephritis in dairy cows should be effective against E.coli.
Why are antimicrobials important for beef production?
Antimicrobials are critical to contemporary high-intensity beef production. Many different antimicrobials are approved for beef cattle, and are used judiciously for animal welfare, and controversially, to promote growth and feed efficiency. Antimicrobial administration provides a powerful selective pressure that acts on the microbial community, selecting for resistance gene determinants and antimicrobial-resistant bacteria resident in the bovine flora. The bovine microbiota includes many harmless bacteria, but also opportunistic pathogens that may acquire and propagate resistance genes within the microbial community via horizontal gene transfer. Antimicrobial-resistant bovine pathogens can also complicate the prevention and treatment of infectious diseases in beef feedlots, threatening the efficiency of the beef production system. Likewise, the transmission of antimicrobial resistance genes to bovine-associated human pathogens is a potential public health concern. This review outlines current antimicrobial use practices pertaining to beef production, and explores the frequency of antimicrobial resistance in major bovine pathogens. The effect of antimicrobials on the composition of the bovine microbiota is examined, as are the effects on the beef production resistome. Antimicrobial resistance is further explored within the context of the wider beef production continuum, with emphasis on antimicrobial resistance genes in the food chain, and risk to the human population.
Is cephapirin good for bacteria?
... As reported by Sheldon, et al. [27], cephapirin is effective against Gram-positive and anaerobic bacteria. Other authors [35] showed that, because of the -lactamase production, some pathogens, such as A. pyogenes and E. coli, most frequently involved in bovine endometritis, are resistant to this drug. Instead, sulfonamides have a wide spectrum of activity, having effect against both Gram-positive and Gram-negative organisms [28,36]. ...
Abstract
The aim of the study was to determine the in vitro sensitivity of 161 Arcanobacterium pyogenes strains and 99 Escherichia coli strains isolated from the uteri of 312 cows with metritis/endometritis.
Introduction
Inflammation of the bovine genital tract causes economic losses due to longer calving intervals, the costs of extra services and treatment, and increased culling rates ( Knutti et al., 2000, Mateus et al., 2002, Kim and Kang, 2003, Maizon et al., 2004, Drillich et al., 2005, Gilbert et al., 2005, Gautam et al., 2009 ).
Material and methods
Cows with pathological discharges from the genital tract between days 7 and 50 after parturition were examined per rectum and per vaginum and a diagnosis was made according to Sheldon et al. (2006).
Results
From the uterine swabs of cows with clinical metritis and endometritis 161 strains of Arc. pyogenes and 99 strains of E. coli were isolated. Arc. pyogenes in pure culture or with other aerobic bacteria ( E.
Discussion
Species of aerobic bacteria isolated from uterine swabs taken from cows with clinical metritis and endometritis were in accordance with the data of Farca et al., 1997, Königsson et al., 2001, Kaczmarowski et al., 2004, Sheldon et al., 2004b and Williams et al. (2005). Königsson et al. (2001) reported that E. coli, Arc.
Conclusions
Constant monitoring of the antibiotic resistance patterns of aetiological agents of bovine uterine inflammation is needed. Routine monitoring may be an important tool for detecting trends in the resistance of bacteria that cause disease in farm animals.
Conflict of interest statement
None of the authors of this paper has a financial or personal relationship with other people or organizations that could inappropriately influence or bias the content of the paper.
What subunit does azithromycin block?
Azithromycin acts by binding to the 50S ribosomal subunit of susceptible microorganisms and blocks dissociation of peptidyl tRNA from ribosomes, causing RNA-dependent protein synthesis to arrest. Nucleic acid synthesis is not affected.
How often should I take erythromycin?
When twice-daily dosing is desired, half of the total daily dose may be taken every 12 hours. For more severe infections, double the dose. While no controlled studies have been performed, erythromycin has been effective in case series and most strains are susceptible. Azithromycin (Zithromax)
Can pharyngitis be treated with penicillin?
No controlled trials of antimicrobial therapy have been conducted for pharyngitis caused by A haemolyticum. Many patients with pharyngitis have been treated with 1 dose of intramuscular penicillin or 7-10 days of erythromycin or oral penicillin. [ 41] Antibiotic sensitivity testing reveals that most strains are resistant to trimethoprim-sulfamethoxazole; tetracycline resistance has been observed in 30% of strains tested. [ 5, 64] An isolate reported in 2006 was also resistant to ciprofloxacin. [ 29] Virtually all strains of A haemolyticum studied so far are sensitive to erythromycin, azithromycin, gentamicin, and clindamycin. [ 5, 65] The majority of isolates are susceptible to penicillin, although tolerance has been reported. Accordingly, macrolides are now considered the drugs of choice. [ 41, 42, 43]
Does erythromycin inhibit bacterial growth?
Erythromycin inhibits bacterial growth, possibly by blocking dissociation of peptidyl tRNA from ribosomes, arresting RNA -dependent protein synthesis. It is for the treatment of staphylococcal and streptococcal infections. In children, age, weight, and severity of infection determine proper dosage.
Is vancomycin good for systemic infections?
More serious systemic infections have been treated successfully with high-dose intravenous beta-lactams (eg, penicillin, ampicillin, amoxicillin, cefuroxime, cefotaxime). Vancomycin is also an acceptable choice for serious infections; however, one strain carries the vanA gene, which is resistant to vancomycin. [ 68] .
Is a haemolyticum sensitive to penicillin?
Virtually all strains of A haemolyticum studied so far are sensitive to erythromycin, azithromycin, gentamicin, and clindamycin. [ 5, 65] The majority of isolates are susceptible to penicillin, although tolerance has been reported. Accordingly, macrolides are now considered the drugs of choice. [ 41, 42, 43]
What is Trueperella pyogenes?
Trueperella (T.) pyogenes is an opportunistic pathogen that causes suppurative diseases in domestic animals. In this work, the properties, pathogenesis and phenotypic diversity of T. pyogenes isolates from bovine mastitis were studied. Both pyolysin (plo) and collagen-binding protein (cbp) virulence factor genes were detected by PCR in all T.
What percentage of T. pyogenes is mastitis?
The intracellular assay revealed that T. pyogenes isolates had different cytopathogenic effects on cells. The high percentage (28.6%) of T. pyogenes isolates suggests that this bacterium is an important contributor to mastitis.
Is Trueperella pyogenes an opportunistic pathogen?
Properties and antimicrobial susceptibility of Trueperella pyogenes isolated from bovine mastitis in China. Trueperella (T.) pyogenes is an opportunistic pathogen that causes suppurative diseases in domestic animals.
